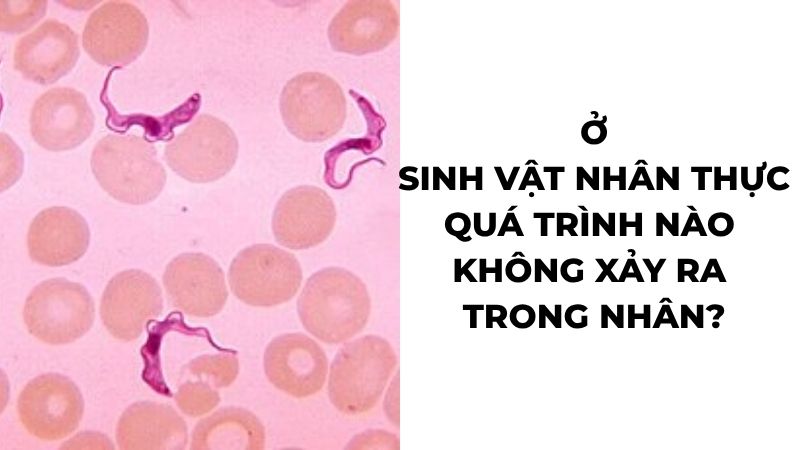
Ở sinh vật nhân thực quá trình nào không xảy ra trong nhân?

Ở sinh vật nhân thực quá trình nào không xảy ra trong nhân?
Mục lục
Ở sinh vật nhân thực, quá trình không xảy ra trong nhân tế bào là dịch mã (tổng hợp chuỗi pôlipeptit). Đây là kiến thức sinh học lớp 12 thường xuất hiện trong các đề thi tốt nghiệp THPT. Bài viết dưới đây giải thích rõ đáp án, lý do và phân biệt vị trí diễn ra của các quá trình phân tử quan trọng trong tế bào nhân thực.
Ở sinh vật nhân thực, quá trình nào sau đây không xảy ra trong nhân tế bào?
Đáp án: Dịch mã (tổng hợp chuỗi pôlipeptit) là quá trình không xảy ra trong nhân tế bào của sinh vật nhân thực. Quá trình dịch mã diễn ra hoàn toàn ở tế bào chất, tại các ribôxôm tự do hoặc ribôxôm gắn trên màng lưới nội chất hạt.
Trong khi đó, ba quá trình còn lại đều diễn ra bên trong nhân tế bào: nhân đôi ADN (tái bản ADN), nhân đôi nhiễm sắc thể, và phiên mã (tổng hợp ARN). Đây là cơ sở để phân biệt chức năng của nhân tế bào và tế bào chất trong sinh vật nhân thực.
Tại sao dịch mã không xảy ra trong nhân tế bào?
Ở sinh vật nhân thực, quá trình phiên mã tạo ra phân tử mARN sơ khai ngay trong nhân tế bào. Tuy nhiên, mARN sơ khai này chưa thể tham gia dịch mã ngay — phân tử phải trải qua quá trình cắt bỏ các đoạn intron (đoạn không mã hóa) và nối các đoạn exon lại để hình thành mARN trưởng thành.
Sau khi hoàn thiện, mARN trưởng thành chui qua các lỗ nhân trên màng nhân để di chuyển ra tế bào chất. Tại đây, các ribôxôm tiếp xúc với mARN và bắt đầu quá trình tổng hợp chuỗi pôlipeptit. Theo Wikipedia về dịch mã, ở sinh vật nhân chuẩn, dịch mã xảy ra trong cytosol hoặc trên màng của mạng lưới nội chất — không phải trong nhân.
Sự phân tách này tạo ra một cơ chế kiểm soát chặt chẽ: nhân tế bào chỉ chịu trách nhiệm lưu trữ và sao chép thông tin di truyền, còn việc “thực thi” thông tin đó — tổng hợp protein — được thực hiện tại tế bào chất.
Tổng hợp: Vị trí diễn ra các quá trình phân tử ở sinh vật nhân thực
Để ghi nhớ chắc chắn cho kỳ thi, bảng dưới đây tóm tắt vị trí diễn ra của bốn quá trình phân tử cốt lõi ở sinh vật nhân thực:
| Quá trình | Vị trí diễn ra | Sản phẩm |
|---|---|---|
| Nhân đôi ADN (tái bản ADN) | Nhân tế bào | 2 phân tử ADN con |
| Nhân đôi nhiễm sắc thể | Nhân tế bào | NST kép (nhiễm sắc tử chị em) |
| Phiên mã (tổng hợp ARN) | Nhân tế bào | mARN, tARN, rARN |
| Dịch mã (tổng hợp chuỗi pôlipeptit) | Tế bào chất (ribôxôm) | Chuỗi pôlipeptit → protein |
Lưu ý quan trọng: ở sinh vật nhân sơ (vi khuẩn), cả phiên mã lẫn dịch mã đều diễn ra ở tế bào chất vì không có màng nhân. Đây là điểm phân biệt then chốt giữa nhân sơ và nhân thực mà đề thi thường khai thác.
Câu hỏi thường gặp về quá trình xảy ra trong nhân tế bào
Dịch mã ở sinh vật nhân thực diễn ra tại bộ phận nào cụ thể?
Dịch mã diễn ra tại ribôxôm trong tế bào chất — có thể là ribôxôm tự do hoặc ribôxôm gắn trên màng lưới nội chất hạt.
Phiên mã và dịch mã có thể xảy ra đồng thời không?
Ở sinh vật nhân thực thì không — phiên mã kết thúc trong nhân trước, mARN trưởng thành mới ra tế bào chất để dịch mã.
Quá trình nào ở nhân thực vừa xảy ra trong nhân vừa xảy ra ở tế bào chất?
Không có quá trình nào trong số bốn quá trình trên diễn ra ở cả hai vị trí — mỗi quá trình có vị trí đặc thù riêng biệt.
Tóm lại, dịch mã là quá trình duy nhất trong số nhân đôi ADN, nhân đôi NST, phiên mã và dịch mã không diễn ra trong nhân tế bào của sinh vật nhân thực. Nắm rõ vị trí của từng quá trình — đặc biệt sự khác biệt giữa nhân thực và nhân sơ — giúp học sinh xử lý chính xác các câu hỏi lý thuyết lẫn vận dụng trong đề thi tốt nghiệp THPT môn Sinh học.
Có thể bạn quan tâm
- Cây xanh sử dụng khí gì để quang hợp? Câu đố kiến thức sinh học
- Đội bóng nào được biết đến với biệt danh "Les Olympiens"? Đáp án
- 1dm2 bằng bao nhiêu cm2? Quy đổi đơn vị diện tích nhanh chính xác
- Tiến hóa lớn là gì? Khái niệm và phân biệt với tiến hóa nhỏ
- Núi Everest ở đâu? Vị trí, độ cao và thông tin chinh phục đỉnh
